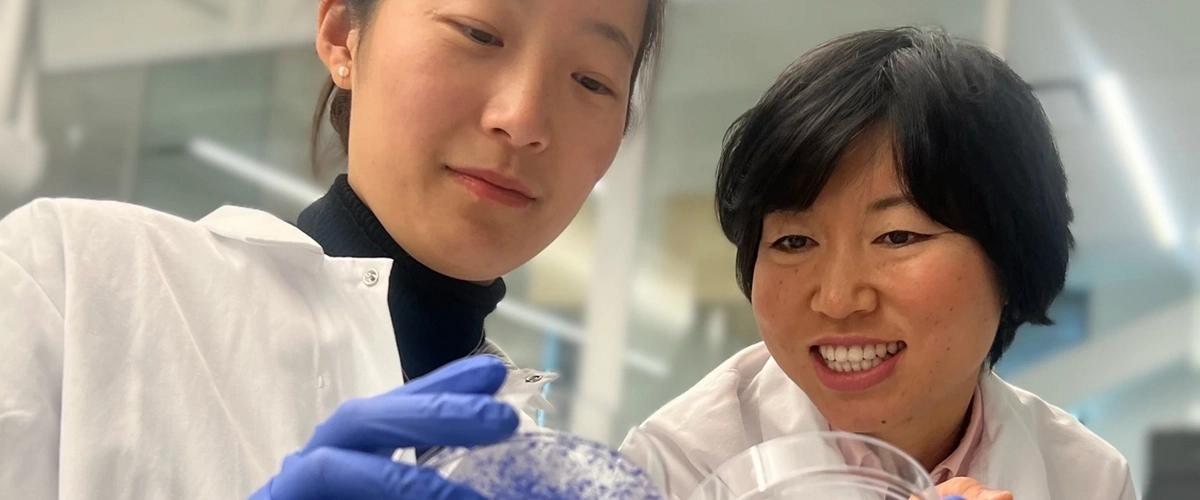
TODO:

Иммунотерапия работает путем блокирования иммунодепрессивного взаимодействия между раковыми клетками и Т-клетками, типом иммунных клеток. Однако для достижения эффективности Т-клетки должны проникать в опухоль. Опухоли, называемые «горячими», такие как меланома и некоторые формы рака легких, хорошо реагируют на лечение иммунотерапией, так как происходит инфильтрация Т-клеток в опухоль. Однако многие другие типы опухолей, такие как рак молочной железы и поджелудочной железы, считаются «холодными», поскольку они не привлекают достаточно Т-клеток.
Исследователи стремились преобразовать холодные опухоли в горячие и обратили внимание на молекулу cGAMP. Когда клетки становятся раковыми и их ДНК повреждается, производится эта молекула. cGAMP активирует иммунный ответ через путь STING, что способствует «разогреву» опухоли. Было обнаружено, что cGAMP экспортируется из клеток, но часто, прежде чем она успевает вызвать ответ, белок ENPP1 разрушает эти молекулярные сигналы опасности. Ученые предположили, что именно ENPP1 помогает сохранять опухоли в холодном состоянии.
ENPP1 вырабатывается раковыми и здоровыми клетками внутри и вокруг опухоли. Высокие уровни ENPP1 у пациентов связаны с резистентностью к иммунотерапии и последующими метастазами, а также коррелируют с плохим прогнозом при многих видах рака. Уровни ENPP1 естественным образом различаются у разных людей. Команда изучила данные пациентов, участвовавших в исследовании I-SPY 2, чтобы увидеть, как реакция на иммунотерапию менялась в зависимости от уровней ENPP1 на момент постановки диагноза.
Пациенты с высокими уровнями ENPP1 имели низкий ответ на иммунотерапию и высокую вероятность метастазов. А пациенты с низким уровнем ENPP1 имели высокий ответ на иммунотерапию и отсутствие метастазов. ENPP1 предсказал как ответ на иммунотерапию, так и вероятность рецидива. Таким образом, ENPP1 имеет решающее значение при метастазах, а не только в первичных опухолях. Поэтому этот белок следует искать в здоровых клетках, а не только в раковых.
В серии экспериментов на мышах ученые доказали, что полное удаление ENPP1 или устранение только его способности разрушать cGAMP в нормальных и раковых клетках дает одинаковый результат — снижение роста опухоли и уменьшение метастазов. Команда также подтвердила, что это результат непосредственного подавления пути STING. То есть ENPP1 работает как некий выключатель иммунного ответа.
Иммунные пути функционируют как каскады сигналов, которые запускают последующие действия, приводящие к иммунному ответу. Белок ENPP1 действует как преграда или «плотина», блокирующая эти сигналы и ограничивающая обнаружение раковых клеток иммунной системой. Уровни ENPP1 могут использоваться для определения подходящего лечения и улучшения эффективности существующих методов борьбы с раком молочной железы. Ингибиторы ENPP1 могут быть потенциальными лекарственными препаратами для усиления эффекта иммунотерапии и лечения всех «холодных» опухолей.